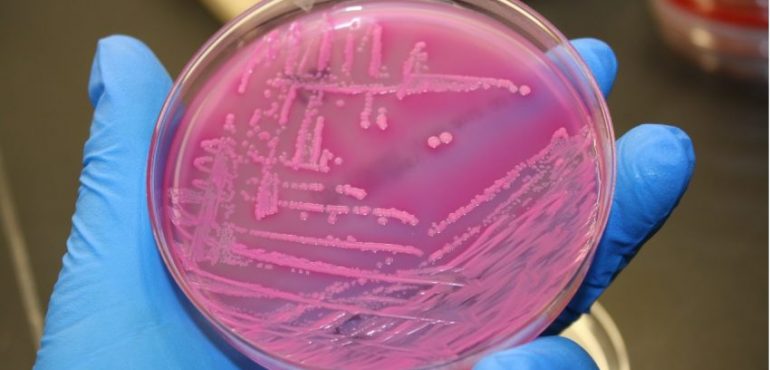

For years, public health experts have warned us that deadly bacteria are developing resistance to all our available antibiotics. This week, researchers reported the first known U.S. case of anEscherichia coli infection resistant to colistin, a harsh drug seen as a last resort to knock out stubborn infections. The finding, described in the American Society for Microbiology journalAntimicrobial Agents and Chemotherapy, is no big surprise to researchers tracking the rise of resistant bacteria. The resistance gene, known as mcr-1, was discovered in E. coli in China last year, and has since cropped up in Europe.
As the United States crosses the same ominous milestone, research to understand resistance and develop new drugs is surging ahead. As Science reported earlier this month, evolutionary biologists have recently revisited old dogma about how best to prescribe antibiotics—revealing that trusted strategies such as using a high dose may not actually help prevent resistance.
Other research has focused on designing new antibiotics that bacterial evolution hasn’t yet anticipated. Last week, chemists at Harvard University described a powerful way to make new variations on the widely used class of antibiotics known as macrolides—a finding that spurred a new company. Meanwhile, governments are trying to find ways to incentivize the costly development of antibiotics—but as a Science feature detailed last year, an unfriendly market makes it hard to persuade companies that the search can be profitable. A new report from U.K. economist Jim O’Neill, also released last week, proposes a list of solutions to the resistance crisis, from new meat labeling practices to $1 billion incentives for drug companies.
AAAS | Full Article